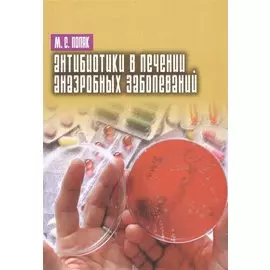
Антибиотики в лечении анаэробных заболеваний

Вы находитесь на странице "учебники по литературе нестор-история спб". Здесь представлены товары российских и зарубежных компаний в количестве 54 шт., включая популярные мировые бренды. Доставка из интернет-магазинов возможна в такие города России как: Москва, Санкт-Петербург, Новосибирск, Екатеринбург, Казань, Нижний Новгород, Челябинск, Красноярск, Самара, Уфа, Ростов-на-Дону, Омск, Краснодар, Воронеж, Волгоград, Пермь и др. Каталог включает как доступные по цене товары, так и продукцию люксового сегмента.
-
 Нестор-История СПб809 ₽
Нестор-История СПб809 ₽РОССИЯ – США: партнерство во имя будущего. Восстановление упущенных возможностей. 1994–2017 годы | Научное издание посвящено вопросам созидательного партнерского политического, социального, культурног...
-
 Нестор-История СПб389 ₽
Нестор-История СПб389 ₽И горит над рябиною спелой незакрытого неба окно… | Книга эта не только и даже не столько образчик литературы в прозе и стихах, а скорее иллюстрация своеобразия и непредсказуемости пути развития лично...
-
 Нестор-История СПб1037 ₽809 ₽-21%
Нестор-История СПб1037 ₽809 ₽-21%Русская тема в европейской литературе | Академик М. П. Алексеев (1896-1981) - выдающийся отечественный филолог, один из зачинателей и крупнейших представителей сравнительного изучения литератур. Воспр...
-
 Нестор-История СПб1249 ₽
Нестор-История СПб1249 ₽D.S.M Д.П. Святополк. Годы эмиграции 1920-1932 | Книга посвящена деятельности выдающегося историка литературы и литературного критика кн. Д. П. Святополк-Мирского (1890-1939) в период его эмиграции (1...
-
 Нестор-История СПб1019 ₽
Нестор-История СПб1019 ₽Испанская литература в русских переводах и критике. Библиография | Библиография охватывает период с середины XVIII века по 1931 год и заполняет существенный пробел в ряду справочных изданий по истории...
-
 Нестор-История СПб1309 ₽
Нестор-История СПб1309 ₽Кампыртепа — кушанская крепость на Оксе. Археологические исследования 2001– 2010 гг. / Отв. редактор | Взаимоотношения А. П. Платонова с его писательским окружением рассматриваются в контексте литерат...
-
 Нестор-История СПб759 ₽509 ₽-32%
Нестор-История СПб759 ₽509 ₽-32%Страсти в пустыне. Повести и рассказы | Неторопливое, несуетное развитие событий, сосредоточенность на оттенках настроений и чувств, лирические интонации характерны для прозы Николая Пороховника.Его п...
-
 Нестор-История СПб829 ₽
Нестор-История СПб829 ₽Нелинейная теория электронной эмиссии | Рассмотрены вопросы, связанные с учетом нелинейности распределения потенциала в прикатодной области. Особое внимание уделено учету дискретности распределения за...
-
![Этноментальность в художественной прозе русской эмиграции: Харбин, 1920-е - 1930-е гг.]() Нестор-История СПб1592 ₽1241 ₽-22%
Нестор-История СПб1592 ₽1241 ₽-22%Этноментальность в художественной прозе русской эмиграции: Харбин, 1920-е - 1930-е гг. | Монография посвящена анализу художественного освоения дальневосточной этноментальности в творчестве писателей х...
-
![Благородные порывы]() Нестор-История СПб499 ₽
Нестор-История СПб499 ₽Благородные порывы | Сборник фантастических рассказов и стихов о жизни разных людей. О болезнях, их начале и финале. Об изменениях состояний и мировоззрений. Сборник о кладах, зарытых в глубинах челов...
-
![Многомасштабные ударно-волновые процессы в твердых телах]() Нестор-История СПб1989 ₽
Нестор-История СПб1989 ₽Многомасштабные ударно-волновые процессы в твердых телах | В монографии отражены результаты экспериментального и теоретическо-го исследования механического поведения твердотельных материалов в условия...
-
![Выйти из учительской. Отечественные экранизации детской литературы в контексте кинопроцесса 1968–1985 гг.]() Нестор-История СПб1155 ₽901 ₽-21%
Нестор-История СПб1155 ₽901 ₽-21%Выйти из учительской. Отечественные экранизации детской литературы в контексте кинопроцесса 1968–1985 гг. | В исследуемый период (1968–1985), который автор подразделяет на послеоттепельный и предперес...
-
![Утонувшие во времени]() Нестор-История СПб1415 ₽1103 ₽-22%
Нестор-История СПб1415 ₽1103 ₽-22%Утонувшие во времени | Герои книги, в основном московская интеллигенция, относятся к поколению людей, чье раннее детство совпало или с годами войны, или с послевоенным тяжелым временем, — поколению "д...
-
![Историческая политика в странах бывшей Югославии]() Нестор-История СПб2241 ₽1681 ₽-24%
Нестор-История СПб2241 ₽1681 ₽-24%Историческая политика в странах бывшей Югославии | В коллективной монографии рассматриваются множественные аспекты исторической политики в странах бывшей Югославии. В первом разделе обсуждаются формир...
-
![Мастерская – артель – завод. Камнерезное искусство Среднего Урала первой половины XX века]() Нестор-История СПб2831 ₽2123 ₽-25%
Нестор-История СПб2831 ₽2123 ₽-25%Мастерская – артель – завод. Камнерезное искусство Среднего Урала первой половины XX века | Код номенклатуры: 978-5-4469-2228-4. nodiscount: no. Категория: Научно-популярная литература/Философские нау...
-
![Русская тема в мировой литературе]() Нестор-История СПб1592 ₽1241 ₽-22%
Нестор-История СПб1592 ₽1241 ₽-22%Русская тема в мировой литературе | В коллективной монографии демонстрируется, как частные события отечественной истории, через литературы стран Востока и Запада, не только формируют образ России в ми...
-
![Был целый мир. Книга о Георгии Иванове]() Нестор-История СПб4365 ₽3403 ₽-22%
Нестор-История СПб4365 ₽3403 ₽-22%Был целый мир. Книга о Георгии Иванове | Книга «Был целый мир» петербургского писателя, историка литературы, эссеиста А. Ю. Арьева — об одном из самых известных поэтов русского зарубежья XX века, счит...
-
![Любование ученым сословием. Отражение социальной истории советской науки в литературе, искусстве и публичной риторике]() Нестор-История СПб1989 ₽
Нестор-История СПб1989 ₽Любование ученым сословием. Отражение социальной истории советской науки в литературе, искусстве и публичной риторике | Настоящее издание посвящено тому, как тема науки и ученых отражалась в публичной...
-
![Психическая норма и патология]() Нестор-История СПб919 ₽717 ₽-21%
Нестор-История СПб919 ₽717 ₽-21%Психическая норма и патология | Книга психиатра Владимира Пшизова состоит из 4 глав, не связанных между собой по содержанию, но общая идея у всех 4-х частей прослеживается: границы психической нормы и...
-
![Эйнштейн - Птолемей релятивизма]() Нестор-История СПб329 ₽
Нестор-История СПб329 ₽Эйнштейн - Птолемей релятивизма | Эта брошюра является сокращенной версией 2 части книги "Попурри на тему ума". Полная версия теории излагается на приложенном диске. В случае утери диска каждый желающ...
-
![Из истории русской переводной художественной литературы первой четверти XIX века]() Нестор-История СПб1019 ₽
Нестор-История СПб1019 ₽Из истории русской переводной художественной литературы первой четверти XIX века | Из истории русской переводной художественной литературы первой четверти XIX века : сб. статей и материалов. — СПб. : ...
-
![Голос из прошлого. 1 серия. Отрывки из книги М.Н. Медведева и С.Е. Соловьева «По невидимым следам»]() Нестор-История СПб339 ₽
Нестор-История СПб339 ₽Голос из прошлого. 1 серия. Отрывки из книги М.Н. Медведева и С.Е. Соловьева «По невидимым следам» | Предлагаем вашему вниманию книгу "Голос из прошлого. 1 серия. Отрывки из книги М.Н. Медведева и С.Е...
-
![Пространство безграничной словесности. Сборник статей к 70-летию В.Е. Багно]() Нестор-История СПб1879 ₽
Нестор-История СПб1879 ₽Пространство безграничной словесности. Сборник статей к 70-летию В.Е. Багно | Сборник, посвященный 70-летию Всеволода Евгеньевича Багно, включает в себя статьи по истории зарубежных литератур, а также...
-
![Горизонты прочтения]() Нестор-История СПб1019 ₽
Нестор-История СПб1019 ₽Горизонты прочтения | В книгу вошли работы, тематически объединенные в четыре раз-дела. Ее организующим центром являются наблюдения над реалиями древнерусской книжной культуры. Особый раздел образуют ...
-
![Тексты и комментарии. Из материалов к истории русской литературы первой трети XX века]() Нестор-История СПб1409 ₽
Нестор-История СПб1409 ₽Тексты и комментарии. Из материалов к истории русской литературы первой трети XX века | Книга представляет собой сборник статей и публикаций А. В. Лаврова, петербургского филолога, и включает его мног...
-
![Гамлет. Трагедия Гамлета, принца Датского]() Нестор-История СПб2241 ₽1747 ₽-22%
Нестор-История СПб2241 ₽1747 ₽-22%Гамлет. Трагедия Гамлета, принца Датского | «Гамлет» — самая знаменитая пьеса Шекспира. Андрей Чернов и издательство «Нестор-История» предлагают новый ее комментированный перевод. В действии на сцене ...
-
![Холодное солнце]() Нестор-История СПб199 ₽
Нестор-История СПб199 ₽Холодное солнце | Книга посвящена реальным событиям, которые произошли в 1960-1970-е годы. Код номенклатуры: ORS970279383659947. nodiscount: no. Категория: Художественная литература/Проза/Современная ...
-
![Проблемы инновационного развития и экологической безопасности. Материалы международной научно-практической конференции (Санкт-Петербург, 29-30 сентября 2014 г.)]() Нестор-История СПб619 ₽
Нестор-История СПб619 ₽Проблемы инновационного развития и экологической безопасности. Материалы международной научно-практической конференции (Санкт-Петербург, 29-30 сентября 2014 г.) | Сборник содержит полные тексты и тези...
-
![Многоликая бездна: формирование новой парадигмы образа растения во французской литературе XIX века]() Нестор-История СПб1415 ₽1103 ₽-22%
Нестор-История СПб1415 ₽1103 ₽-22%Многоликая бездна: формирование новой парадигмы образа растения во французской литературе XIX века | В монографии изучается феномен «глубины» образа растения с новой парадигмой, возникшей на рубеже XV...
-
![Лазерные методы и средства экологического]() Нестор-История СПб809 ₽
Нестор-История СПб809 ₽Лазерные методы и средства экологического | В пособии основное внимание уделяется таким эффективным лазерным методам дистанционного зондирования атмосферы, как метод комбинационного рассеяния, индуцир...
-
![Контроль и мониторинг воздействия стационарных и нестационарных энергетических установок на окружающ]() Нестор-История СПб919 ₽717 ₽-21%
Нестор-История СПб919 ₽717 ₽-21%Контроль и мониторинг воздействия стационарных и нестационарных энергетических установок на окружающ | сновное внимание уделяется изучению воздействия стационарных и нестационарных энергетических уста...
-
![Сквозные мотивы русской драматургии: От Грибоедова до Эрдмана]() Нестор-История СПб1155 ₽901 ₽-21%
Нестор-История СПб1155 ₽901 ₽-21%Сквозные мотивы русской драматургии: От Грибоедова до Эрдмана | Исследования русской классической драматургии до недавнего времени не стремились выявить лейтмотивы русской драмы на большом массиве тек...
-
![Поиск новых чисел]() Нестор-История СПб565 ₽441 ₽-21%
Нестор-История СПб565 ₽441 ₽-21%Поиск новых чисел | Прослежено рождение чисел с натуральных чисел по комплексные. Получен закон построения новых чисел на основе уже известных чисел. По этому закону построены «четвёртые числа» и «пят...
-
![Обоснование фидуциального подхода]() Нестор-История СПб311 ₽259 ₽-16%
Нестор-История СПб311 ₽259 ₽-16%Обоснование фидуциального подхода | Автор «Самостоятельного байесовского подхода» здесь дает обновлённую процедуру получения фидуциальной интервальной оценки параметра, которая теперь имеет обоснованн...
-
![Мариванна. Талисман Зюрат Куль]() Нестор-История СПб1592 ₽1241 ₽-22%
Нестор-История СПб1592 ₽1241 ₽-22%Мариванна. Талисман Зюрат Куль | Как и в первой книге, во втором сборнике хотелось коснуться различных актуальных тем, а также темы отношений между природой и человеком. Невозможно обойти стороной тем...
-
![Достоевский: этимология повествования]() Нестор-История СПб1415 ₽1103 ₽-22%
Нестор-История СПб1415 ₽1103 ₽-22%Достоевский: этимология повествования | Это книга о рождении художественного слова Ф. М. Достоевского. Пять глав в разных аспектах рассказывают о том, как формировалось повествование, которым восхищае...
-
![Избранное: Статьи, переводы, комментарии]() Нестор-История СПб1297 ₽1011 ₽-22%
Нестор-История СПб1297 ₽1011 ₽-22%Избранное: Статьи, переводы, комментарии | В книгу избранных статей, переводов и комментариев вошли работы, посвященные изучению «Слова о полку Игореве», жизни и творчества А. С. Пушкина и поэмы А. А....
-
![Россия на пути консолидации: Сборник статей.]() Нестор-История СПб809 ₽
Нестор-История СПб809 ₽Россия на пути консолидации: Сборник статей. | В книге дан философский и социологический анализ фундаментальных ценностей, определивших цивилизационный выбор России, прослежен процесс поиска Россией с...
-
![Ребята которые любят думать]() Нестор-история Спб128 ₽
Нестор-история Спб128 ₽Ребята которые любят думать | Предлагаем вашему вниманию книгу Риммы Цветковской "Ребята, которые любят думать". Категория: проза для детей. повести, рассказы, детская художественная литература.
-
![Ребятам нашей эпохи посвящается Литературные портреты наших любимцев Серия 3]() Нестор-история Спб77 ₽
Нестор-история Спб77 ₽Ребятам нашей эпохи посвящается Литературные портреты наших любимцев Серия 3 | Вашему вниманию предлагается Сборник рассказов для детей "Ребятам нашей эпохи посвящается. Литературные портреты наших лю...
-
![Для Павловского и Прохорова раковая опухоль пустяк Учебно-познавательная литература на заметку медикам и потенциальным больным]() Нестор-история Спб80 ₽
Нестор-история Спб80 ₽Для Павловского и Прохорова раковая опухоль пустяк Учебно-познавательная литература на заметку медикам и потенциальным больным | Категория: альтернативная и народная медицина, популярная медицина.
-
![Русский фольклор Том XXXVII]() Нестор-история Спб792 ₽
Нестор-история Спб792 ₽Русский фольклор Том XXXVII | Категория: фольклор, художественная литература.
-
![Донна Анно]() Нестор-история Спб159 ₽135 ₽-15%
Нестор-история Спб159 ₽135 ₽-15%Донна Анно | Категория: проза для детей. повести, рассказы, детская художественная литература.
-
![Антибиотики в лечении анаэробных заболеваний]() Нестор-История СПб409 ₽278 ₽-32%
Нестор-История СПб409 ₽278 ₽-32%Антибиотики в лечении анаэробных заболеваний | Антибиотикотерапия является важным компонентом комплекса лечебных мероприятий при заболеваниях, вызванных облигатно анаэробными бактериями (родов Bactero...
-
![Пепел Клааса]() Нестор-История СПб329 ₽
Нестор-История СПб329 ₽Пепел Клааса | Писатель Шарль де Костер написал в 1867 г. книгу "Легенда об Уленшпигеле". Книга стала классикой бельгийской литературы. Вошла в сокровищницу мировой литературы. . .Тиль Уленшпигель пат...
-
![Нострадамус глазами исторической науки]() Нестор-история Спб384 ₽
Нестор-история Спб384 ₽Нострадамус глазами исторической науки | Автор подходит к творчеству Нострадамуса как к культурному феномену, базирующемуся на интерпретации предшественников и неизбежном выражении любых пророчеств на...
-
![Самостоятельный байесовский подход]() Нестор-История СПб249 ₽
Нестор-История СПб249 ₽Самостоятельный байесовский подход | Дан байесовский подход в математической статистике, который поставляет не зависимые от параметра решения. Этим становится решенной проблема байесовского подхода к ...
-
![Антибиотикотерапия проблемных инфекций. Преодоление резистентности]() Нестор-история Спб852 ₽
Нестор-история Спб852 ₽Антибиотикотерапия проблемных инфекций. Преодоление резистентности | Книга посвящена проблеме антибиотикотерапии инфекций, вызванных множественно устойчивыми штаммами микроорганизмов, в том числе "мет...
-
![13. Проблема личной идентификации в немецкоязычной литературе]() Нестор-История СПб619 ₽
Нестор-История СПб619 ₽13. Проблема личной идентификации в немецкоязычной литературе | Сборник «13», названный так по числу представленных в нем статей, посвящен анализу проблемы индивидуалности в немецкоязычной литературе ...
-
![Андрей Платонов и литературная Москва]() Нестор-История СПб1989 ₽
Нестор-История СПб1989 ₽Андрей Платонов и литературная Москва | Взаимоотношения А. П. Платонова с его писательским окружением рассматриваются в контексте литературной жизни Москвы 1920-1940-х гг. Выясняется, почему Платонов ...
-
![Гравитация вне и внутри нас: Сборник научно-популярных статей]() Нестор-История СПб1019 ₽
Нестор-История СПб1019 ₽Гравитация вне и внутри нас: Сборник научно-популярных статей | В монографии в виде отдельных статей рассмотрены некоторые аспекты взаимодействия гравитационного поля с материальными объектами Земли...
-
![Серебряный век. Имена и события]() Нестор-История СПб1399 ₽
Нестор-История СПб1399 ₽Серебряный век. Имена и события | Книга представляет собой собрание статей и публикаций Константина Азадовского, петербургского историка литературы, критика и переводчика, и отражает его многолетние и...
-
![Американский акцент. Статьи о творчестве писателей США XIX-XX веков]() Нестор-История СПб1569 ₽
Нестор-История СПб1569 ₽Американский акцент. Статьи о творчестве писателей США XIX-XX веков | В книге идёт речь о некоторых аспектах творчества и особенностях художественной манеры классиков американской литературы девятнадц...
-
![Взгляд в античность. Varia]() Нестор-История СПб1199 ₽
Нестор-История СПб1199 ₽Взгляд в античность. Varia | Сборник статей профессора Гринбаума объединяет исследования, посвященные изучению языка античной литературы во всем разнообразии ее жанров. .Книга рассчитана на широкий кр...